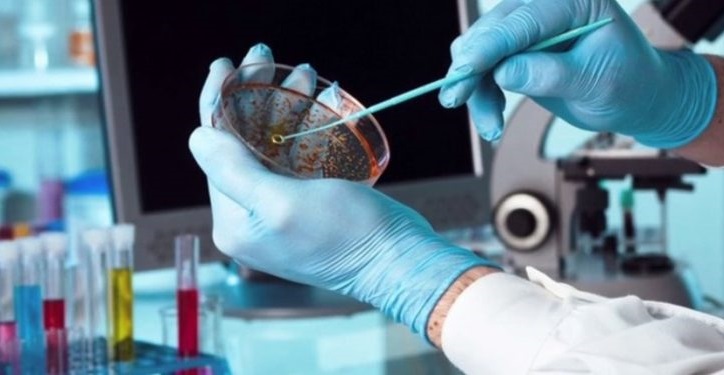
voithos_mikroviologou

Ζητείται Βοηθός Μικροβιολόγου (παρασκευάστρια) με εμπειρία σε αιμοληψίες για εργασία σε ιδιωτικό μικροβιολογικό εργαστήριο στη Λευκάδα.
Απαραίτητα προσόντα:
- Άριστη γνώση αιμοληψιών
- Γνώση Η/Y
Αποστολή βιογραφικών στο e-mail: biolipsis@biolipsis.gr, Τηλ. επικοινωνίας: 26450-22226